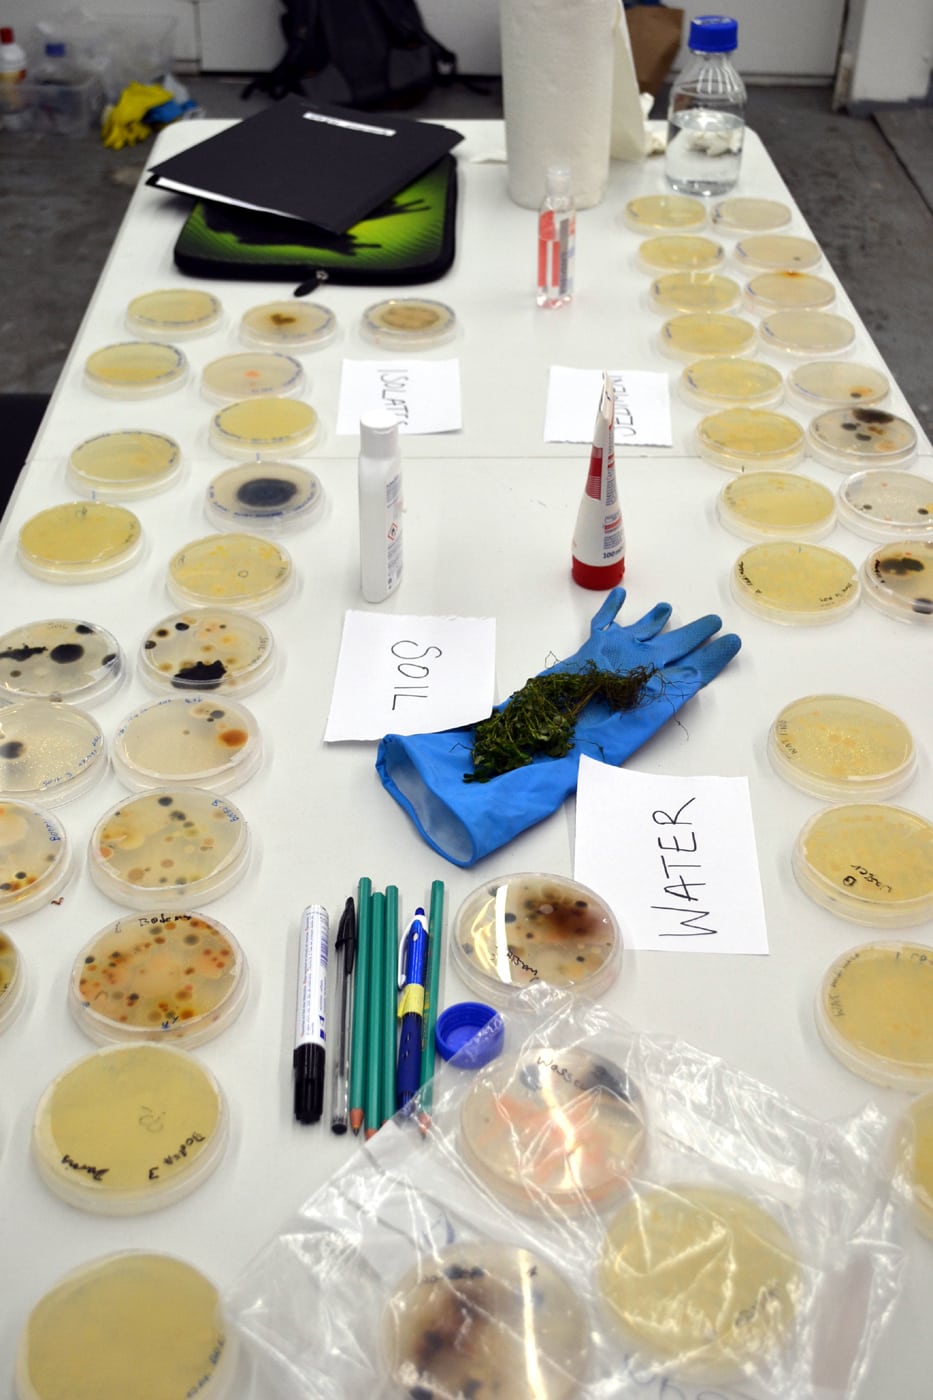

DIY Hack the Panke
Panke Life. Microbiodiversity
Sarah Hermanutz | India Mansour | Fara Peluso
This workshop will research the diversity of invisible life in the Panke River. Choosing a site along the river in Berlin-Wedding artists Fara Peluso and Sarah Hermanutz and microbiologist India Mansour will show participants how to investigate the microbial life and ecologies of an urban waterway. The workshop will explore the river and floodplain as microbial habitats, with special emphasis on water, sediment and soil along the riverbanks. Microbial community characteristics, interactions with the environment, and nutrient cycles will be discussed and examples sought out.
Participants will test the water for signs of a possible Algal bloom in the coming summer, seek out life through microscopy and build their own Winogradsky columns, which can visualise bacteria and algae, from Panke mud. These will later bloom into rich visual and biological communities.
Sarah Hermanutz is a visual artist working at the intersections of performance, technology, and ecology. Her sculptures, installations, and performance experiments are preoccupied with wetlands, amphibious creatures, and the mysteries of social cognition. Her artistic research takes place in Berlin at Lacuna Lab, an art and technology collective she co-founded in 2015, and in the media arts department of Bauhaus University Weimar.
India Mansour researches microbial community structure and function in rivers and soils as a postdoc at the Free University, Berlin – Plant Ecology. She is currently focused on the emerging theoretical framework of community coalescence, which investigates the dynamics that occur when previously distinct microbial communities collide in space. She attained a joint PhD in River Science from Free University – Berlin and Queen Mary University in London.
Artist designer Fara Peluso‘s long-term research focuses on potential uses for algae as an environmental regulator, source for sustainable materials, and aesthetic catalyser of biophilia. Her research and practice combine working with biotechnologists and DIY scientists with speculative and critical design to produce a myriad of innovative design and artistic solutions.
DIY Hack the Panke is a collective of artists, scientists and curators exploring the rich historical and ecological heritage of the Panke River in Mitte, Wedding and Pankow. Based at Art Laboratory Berlin, we thank Panke e.V. for their cooperation in this workshop and the Fachbereich Kunst und Kultur Bezirksamt Mitte and the Bezirkskulturfonds for their generous support of our 2019 public programme.